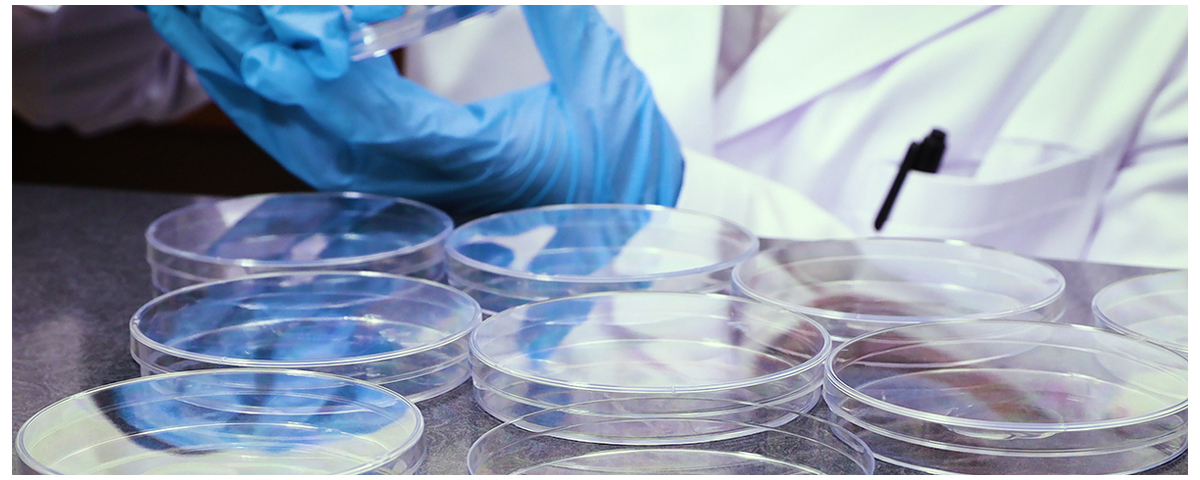

Blog - Aure Chemical
The Key Role of DMSO in Biopharmaceuticals and Cell Cryopreservation
Dimethyl sulfoxide (DMSO) is an organic solvent with unique
polar and aprotic properties, making it highly versatile in various applications. It exhibits high solubility for a wide range of compounds, low toxicity at controlled concentrations, and the ability to penetrate biological membranes, which has made it invaluable in medical and research contexts. DMSO is a colorless liquid that is miscible with water and many organic solvents, and its chemical formula is (CH₃)₂SO.
Historically, DMSO was first synthesized in 1866 by Russian scientist Alexander Zaytsev as a byproduct of wood pulp processing in the kraft paper-making method. Its medical potential was not explored until the 1960s, when Dr. Stanley Jacob at Oregon Health & Science University discovered its ability to penetrate skin and carry other substances with it, sparking interest in its use as a solvent and therapeutic agent. By the mid-20th century, DMSO became widely adopted in biological and pharmaceutical research for cryopreservation, drug delivery, and as a penetration enhancer, despite early controversies over its safety and efficacy that led to FDA scrutiny. Today, it remains a staple in laboratories and clinical settings due to its multifaceted properties.
Role in Biopharmaceuticals
In the biopharmaceutical industry, DMSO serves as a critical solvent for poorly soluble compounds, enhancing drug formulation and improving bioavailability by facilitating the dissolution of active pharmaceutical ingredients (APIs). It is commonly used in drug discovery, API synthesis, and analytical applications, where its ability to dissolve both polar and non-polar substances is particularly beneficial.
DMSO plays a key role in cell-based therapies, such as ex vivo cell expansion or intracellular drug delivery, by acting as a penetration enhancer that allows therapeutic agents to cross cell membranes efficiently. Additionally, it aids in protein stabilization during storage and transport, helping to maintain the structural integrity of biologics like monoclonal antibodies and enzymes by reducing aggregation and denaturation.
Beyond these, DMSO exhibits anti-inflammatory effects and can reduce oxidative stress in biological systems, making it useful in topical applications and as a free radical scavenger. It also induces cellular differentiation and has radioprotective properties, expanding its utility in pharmacological research.
Role in Cell Cryopreservation
DMSO functions as a cryoprotectant by preventing ice crystal formation during the freezing process, which could otherwise rupture cell membranes and cause irreversible damage. Its mechanism involves lowering the freezing point of cellular water, promoting vitrification (a glass-like state) rather than crystallization, and stabilizing cellular structures during both freezing and thawing.
Applications of DMSO in cryopreservation are diverse. It is essential for preserving stem cells, such as hematopoietic stem cells (HSCs) used in bone marrow transplants, where it ensures high post-thaw viability. In immune cell therapies like CAR-T, DMSO protects cells during storage for immunotherapy treatments. It is also widely used in reproductive biology for cryopreserving embryos and oocytes, supporting assisted reproductive technologies.
For optimal usage, DMSO is typically employed at concentrations of 5–10% (v/v) in cryopreservation media, combined with controlled cooling rates (e.g., 1°C/min) to minimize thermal shock, and rapid thawing protocols (e.g., in a 37°C water bath) to maximize cell recovery and viability. These practices are standard in biobanking and clinical cell storage.
Safety and Toxicity Considerations
While effective, DMSO can exhibit cytotoxicity at high concentrations, potentially leading to cell death or altered cellular processes, such as changes in epigenetics and metabolism. In cryopreservation, concentrations above 10% may cause infusional toxicities when cells are administered to patients, including nausea, hypertension, or cardiac issues.
Proper handling involves thorough washing to remove DMSO post-thawing, as residual amounts can affect cell function and patient safety. Regulatory guidelines from bodies like the FDA emphasize controlled use in pharmaceutical and clinical applications, recommending lower concentrations (e.g., 5%) for sensitive cells and validation of cryopreservation protocols. In cell culture, concentrations up to 0.5% are generally safe, but exceeding this requires careful monitoring.
Future Perspectives
The development of DMSO alternatives with lower toxicity is a growing focus, driven by the need for safer cryopreservation in advanced therapies. Promising substitutes include trehalose, polyvinyl alcohol, and bioinspired compounds that achieve vitrification without cytotoxicity, particularly for hematopoietic stem cells and cell-based products. DMSO-free solutions offer enhanced safety for therapeutic applications, reducing risks like batch variability and protein instability in media.
Advances in cryopreservation techniques aim at large-scale biopharmaceutical production, including automated freezing systems and improved vitrification methods for delicate cell types like organoids or iPSCs. Future innovations may enable long-term storage without compromising cell potency, supporting the expansion of cell and gene therapies.
DMSO is a critical component in both biopharmaceutical development and cell preservation, owing to its unique chemical properties that enable it to act as an effective cryoprotectant and solvent while balancing efficacy with manageable safety concerns. As research progresses, its role may evolve alongside safer alternatives, but it remains foundational in advancing medical therapies and biological research.
Why Choose Aure Chemical for Your Dimethyl Sulfoxide Supply?
Aure Chemical is dedicated to providing superior chemical solutions and unparalleled customer support. By partnering with us for your Dimethyl Sulfoxide requirements, you benefit from:
Exceptional Purity & Consistent Quality: Our Dimethyl Sulfoxide is manufactured to stringent purity specifications, crucial for sensitive pharmaceutical, electronics, and chemical synthesis applications. We guarantee consistent performance batch after batch.
Reliable Global Supply Chain: We maintain a robust and efficient supply network, guaranteeing timely and secure delivery of this valuable chemical to your facilities worldwide, adhering to all strict safety and regulatory standards.
Expert Technical Support: Our team of experienced chemists and specialists is readily available to offer comprehensive guidance on product application, safe handling procedures, and optimal storage conditions for Dimethyl Sulfoxide, especially given its hygroscopic nature.
Commitment to Quality & Safety: We adhere to the highest industry standards for quality management, safety, and environmental responsibility across all our operations, ensuring peace of mind for our clients.
Choose Aure Chemical for a trustworthy and dependable supply of high-quality Dimethyl Sulfoxide. We're ready to support your most demanding and innovative industrial processes.
Related Articles
Looking for a reliable bulk supplier of Dimethyl Sulfoxide (DMSO)?
Aure Chemical provides high-purity DMSO raw materials for the pharmaceutical, polymer, and chemical industries.
View our DMSO product page
